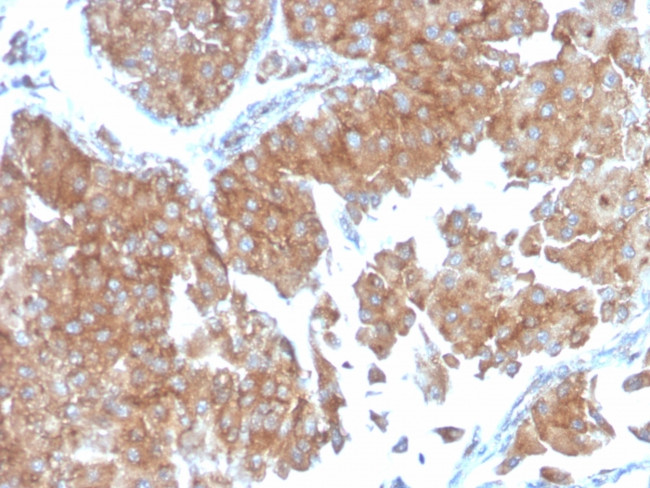
SERBP1/PAI-RBP1 Antibody in Immunohistochemistry (Paraffin) (IHC (P))

Search
NeoBiotechnologies
SERBP1/PAI-RBP1 Monoclonal Antibody (SERBP1, 3498)
{{$productOrderCtrl.translations['antibody.pdp.commerceCard.promotion.promotions']}}
{{$productOrderCtrl.translations['antibody.pdp.commerceCard.promotion.viewpromo']}}
{{$productOrderCtrl.translations['antibody.pdp.commerceCard.promotion.promocode']}}: {{promo.promoCode}} {{promo.promoTitle}} {{promo.promoDescription}}. {{$productOrderCtrl.translations['antibody.pdp.commerceCard.promotion.learnmore']}}
产品信息
26135-MSM8-P1ABX
种属反应
宿主/亚型
分类
类型
克隆号
抗原
偶联物
形式
浓度
规格
纯化类型
保存液
内含物
保存条件
运输条件
产品详细信息
Immunohistochemistry (PFA fixed): incubate antibody for 30 min RT. Staining of formalin-fixed tissues requires heating tissue sections in 10mM Tris with 1mM EDTA, pH 9.0, for 45 min at 95 degrees C followed by cooling at RT for 20 minutes.
靶标信息
SERBP1 may play a role in the regulation of mRNA stability. It binds to the 3'-most 134 nt of the SERPINE1/PAI1 mRNA, a region which confers cyclic nucleotide regulation of message decay.
仅用于科研。不用于诊断过程。未经明确授权不得转售。
篇参考文献 (0)
生物信息学
蛋白别名: chromodomain helicase DNA binding protein 3 interacting protein; PAI RBP 1; PAI-1 mRNA binding protein; PAI-RBP1; PAI1 RNA-binding protein 1; Plasminogen activator inhibitor 1 RNA-binding protein; SERPINE1 mRNA-binding protein 1; unnamed protein product
基因别名: CGI-55; CHD3IP; HABP4L; Hero45; PAI-RBP1; PAIRBP1; SERBP1
UniProt ID: (Human) Q8NC51
Entrez Gene ID: (Human) 26135